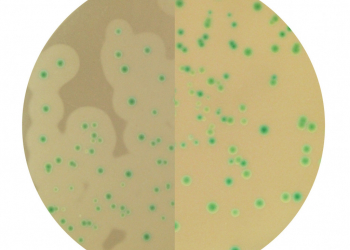
When in doubt, CondaChrome Listeria®

-
ECHA has restricted the use of substances that are key ingredients in the formulation of some culture media mainly used in the cosmetics industry.

Regulation of chemical substances and culture media affected in 2021
Read more
Published: 23/11/20 16:32 | Categories: Microbiology -
The health personnel uses masks as their main barrier to prevent infections caused by biological agents.

Masks and COVID-19. How to validate their quality?
Read more
Published: 23/11/20 16:02 | Categories: Microbiology -
The cannabis market has grown exponentially in recent years. However, there are still no regulations regarding the microbiological control of these products.

Microorganisms hidden in cannabis
Read more
Published: 23/11/20 15:43 | Categories: Microbiology -
One of the great challenges facing the appearance of new emerging pathogens in matters of microbiological safety is to obtain standardized protocols for their analysis.

Do emerging pathogens have a standard method?
Read more
Published: 23/09/20 13:19 | Categories: Microbiology -
Still don't know about our CondaChrome® CCA Coliform Chromogenic Agar? We invite you to learn more about our culture medium for the enumeration of Escherichia coli and coliforms under ISO 9301

Guarantee your results for E. coli and coliforms in drinking water
Read more
Published: 23/09/20 12:38 | Categories: Microbiology -
The control of Legionella spp. it has become one of the priorities for public health. Join us in our CondalabTalk to fine-tune your reference method.

Have you enjoyed our CondalabTalks? A new series coming soon!
Read more
Published: 23/09/20 11:51 | Categories: Microbiology -
One cannot speak of food security without mentioning Listeria due to the danger it poses to public health, however among Listeria spp. and Listeria monocytogenes, which is the most appropriate?
When in doubt, CondaChrome Listeria®
Read more
Published: 28/07/20 13:23 | Categories: Microbiology -
Detecting the new coronavirus in wastewater promises to be the best tool to anticipate outbreaks in any population.

Presence of SARS-CoV-2 in wastewater: risks and opportunities
Read more
Published: 28/07/20 13:11 | Categories: Microbiology
Last blog news
News categories
Search on news

 Microbiology changes its color: The prevalence of chromogenic media
Microbiology changes its color: The prevalence of chromogenic media
 Probiotics: Which ones are good?
Probiotics: Which ones are good?
 Food fraud: How do we detect it?
Food fraud: How do we detect it?
 PCR: The Technique Revolutionizing Rapid Detection in the Food Industry
PCR: The Technique Revolutionizing Rapid Detection in the Food Industry
 Condalab Says YES to the World’s Leading Lab Trade Fair: Analytica 2026
Condalab Says YES to the World’s Leading Lab Trade Fair: Analytica 2026